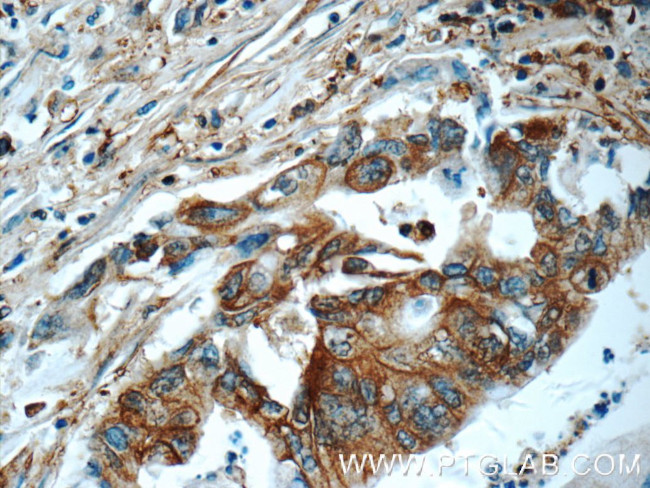
CAP1 Antibody in Immunohistochemistry (Paraffin) (IHC (P))

Search
Proteintech
CAP1 Polyclonal Antibody
{{$productOrderCtrl.translations['antibody.pdp.commerceCard.promotion.promotions']}}
{{$productOrderCtrl.translations['antibody.pdp.commerceCard.promotion.viewpromo']}}
{{$productOrderCtrl.translations['antibody.pdp.commerceCard.promotion.promocode']}}: {{promo.promoCode}} {{promo.promoTitle}} {{promo.promoDescription}}. {{$productOrderCtrl.translations['antibody.pdp.commerceCard.promotion.learnmore']}}
产品信息
16231-1-AP
种属反应
已发表种属
宿主/亚型
分类
类型
抗原
偶联物
形式
浓度
规格
纯化类型
保存液
内含物
保存条件
运输条件
产品详细信息
Immunogen sequence: SKLFNHLSA VSESIQALGW VAMAPKPGPY VKEMNDAAMF YTNRVLKEYK DVDKKHVDWV KAYLSIWTEL QAYIKEFHTT GLAWSKTGPV AKELSGLPSG PSAGSGPPPP PPGPPPPPVS TSSGSDESAS RSALFAQINQ GESITHALKH VSDDMKTHKN PALKAQSGPV RSGPKPFSAP KPQTSPSPKR ATKKEPAVLE LEGKKWRVEN QENVSNLVIE DTELKQVAYI YKCVNTTLQI KGKINSITVD NCKKLGLVFD DVVGIVEIIN SKDVKVQVMG KVPTISINKT DGCHAYLSKN SLDCEIVSAK SSEMNVLIPT EGGDFNEFPV PEQFKTLWNG QKLVTTVTEI AG (125-475 aa encoded by BC013963)
靶标信息
Adenylyl cyclase-associated protein 1 is an enzyme that in humans is encoded by the CAP1 gene. This gene is mapped to 1p34. 2. The protein encoded by this gene is related to the S. cerevisiae CAP protein, which is involved in the cyclic AMP pathway. And the human protein is able to interact with other molecules of the same protein, as well as with CAP2 and actin. Alternatively spliced transcript variants have been identified.
仅用于科研。不用于诊断过程。未经明确授权不得转售。
生物信息学
蛋白别名: adenylate cyclase associated protein 1; adenylyl cyclase-associated CAP protein, yeast homolog 1; Adenylyl cyclase-associated protein 1; CAP 1; CAP, adenylate cyclase-associated protein 1; CAP1; cyclase-associated protein homologue; RP11-115D7.1; testis secretory sperm-binding protein Li 218p; unnamed protein product
基因别名: CAP; CAP1; CAP1-PEN; Mch1
UniProt ID: (Human) Q01518, (Rat) Q08163, (Mouse) P40124
Entrez Gene ID: (Human) 10487, (Rat) 64185, (Mouse) 12331